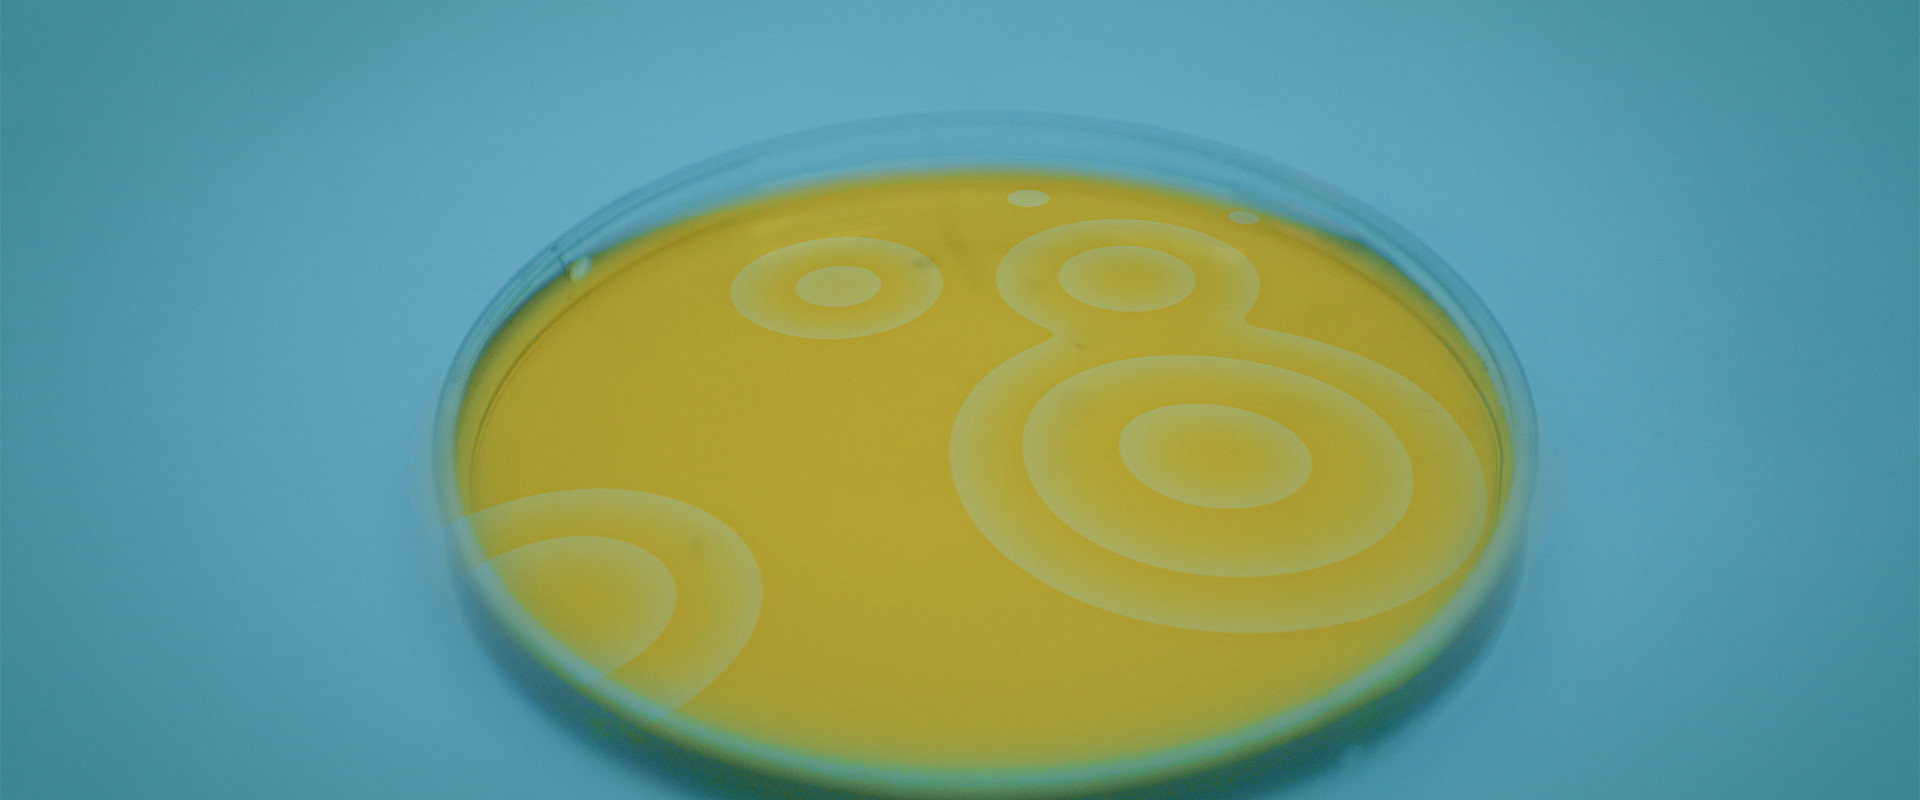
Riproduzione Casuale

演职人员
推荐

近郊奇情
SubUrbia
在德州的一个小镇上,五个徒有梦想却不付诸行动的年轻人,整天在街上瞎晃度日,期待自己有一天能闯出什么名堂来。有一天,高中旧识邦尼返乡探望他们,从此一切都不一样了……

皇后区的某处
Somewhere in Queens
利奥和安吉拉·鲁索在皇后区过着简朴的生活,周围都是傲慢的美籍意大利家庭。当他们的儿子“Sticks”在他的高中篮球队中获得成功时,利奥为了实现这一目标而让家人伤心不已。

听鸟博士的话
Dr. Bird's Advice for Sad Poets
十六岁的詹姆斯·惠特曼是一个敏感、爱好诗歌且深陷焦虑困扰的少年。他的生活一团糟:深爱的姐姐神秘失踪,父母的关系名存实亡,而他自己则快被内心的忧郁吞噬了。为了活下去,詹姆斯在脑海中虚构了一个“心理医生”——一只巨大的、会说话的、充满智慧的信鸽“鸟博士”。在鸟博士那古怪又犀利的建议下,詹姆斯开始走出房门,去寻找姐姐失踪的真相,并试图在这个疯狂的世界里找到属于自己的落脚点。

固定电话
Landline
珍妮·斯蕾特将再与美国女导演吉莉安·罗伯斯比尔合作,拍摄喜剧片《固定电话》(Landline)。这部电影由珍妮·斯蕾特和艾比·奎因主演,两人在影片中饰演姐妹,故事讲述她们发现父亲欺骗母亲后,两人之间的矛盾冲突。该片将于5月23日开拍。

¿Y Cómo Es Él?
Thomas is a meek man on the verge of a nervous breakdown. Despite his situation he decides to fake a work trip to go to Vallarta to confront Jero, a taxi driver who is sleeping with his wife.

采访舞者
Match
一对四十多岁的夫妇来到纽约采访一个芭蕾舞老师,交谈中,他们在艺术方面产生了许多共鸣。

Playing God
A brother and sister con-artist duo find themselves scamming a grieving billionaire by convincing him they can introduce him to God, face-to-face.

上钩
Hooking Up
贝利(萨姆·理查森)和达拉(布列塔尼·斯诺)开始了一种误导和相互欺骗的治疗形式,其中他们必须开车穿越全国,重新再现达拉作为性瘾君子的丰富多彩的历史。随着他们公路旅行的真正动机浮出水面,这对不太可能的情侣们互相强迫他们面对他们的问题,发现实际上可能有更多的爱,而不仅仅是性。